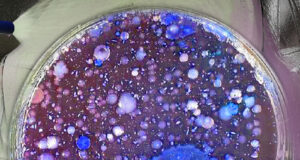
Bakterien im Innenraum

Hersteller News
All
- All
- 2020
- Aktuelle Frage
- Auto
- Automechanika
- Auwa
- Car Wash Show
- carwash Profi Gold-Sponsoren
- carwash Profi Sponsoren
- carwashinfo 2020
- carwashinfo Archiv
- carwashinfo LIVE
- Chemie
- Chemie
- Christ
- Coronavirus COVID-19
- cwi 2023
- cwi 2024
- Do it yourself
- E-Mobilität
- Energie
- Hersteller-News
- Interviews
- Kärcher
- Kurioses
- Messen Ausland
- Messen und Veranstaltungen
- Messeneuheiten
- News
- NuFa
- Online-Archiv
- Portalwaschanlagen
- Produkte
- SB-Plätze
- Social-Media
- Steuer/Recht
- Tankstelle & Mittelstand
- Tips
- UNITI expo
- Video-carwashprofi-2020
- Videos
- Waschmaterial
- Waschstraßen
- Waschstraßen
- WashTec
- Wasser
- Wasser
- Wasseraufbereitung
Konsequente Klimastrategie
WashTec investiert in Nachhaltigkeit
WashTec, der führende Anbieter von Lösungen für die Fahrzeugwäsche, hat am 06.06.2024 die erste Photovoltaik-Anlage am Standort Augsburg in Betrieb genommen....
Istobal stellt Ozon-in-Wasser Reinigungssystem vor
Ozone Jet Wash ist nachhaltiger, effizienter und kostengünstiger als Heißwasserboiler, reduziert den Wartungsaufwand der Anlage und erzielt eine optimale Waschqualität.
ISTOBAL, die führende spanische Gruppe...
Vegane Fahrzeugpflege ohne Kompromisse
Dr.Stöcker erhält begehrte Vegan-Zertifizierung von Vriendly.org für sein Fahrzeugpflegesortiment
Die Chemische Fabrik Dr.Stöcker, einer der führenden Anbietern von Reinigungs- und Pflegeprodukten für Fahrzeuge aller Art,...
Findet überall ihren Platz
Wirtschaftlich und kompakt: Neue Kärcher Portalwaschanlage CW 1 Klean!Fit
Winnenden, September 2022 – Mit der CW 1 Klean!Fit bringt Kärcher eine neue Portalwaschanlage der Einstiegsklasse...
Reinigungs- und Pflegelösungen fürWerkstätten und Autohäuser
Kärcher auf der Automechanika 2022:Halle 8.0, Stand B28 und Halle 12.0, Stand A51
Auf der Automechanika 2022, die vom 13. bis zum 17. September in...
Goodbye GENIUS
18 Jahre Christ Autowaschanlage C 160 GENIUS - Ein Meilenstein der Innovation
Die Christ Autowaschanlage C 160 Genius feierte ihr18-jähriges Bestehen mit der Fertigstellung...
Mit Christ auf Hochtouren
Best-Practice-Story, Autohaus Lenz, Geschäftsführer Frank Lenz
Das Autohaus Lenz im nordrhein-westfälischen Oelde-Stromberg zählt zu den größeren Autohändlern Deutschlands. Für die Wäsche und Pflege vieler Neu-...
Weltmarktführer stellt Weichen für die Zukunft
Personelle Veränderungen im Vorstand der Alfred Kärcher SE & Co. KG
Kärcher hat zum Jahresbeginn zwei Vorstandsposten neu besetzt und stellt damit die Weichen für...
Messen & Veranstaltungen
Besucherregistrierung für Carwash Show Nashville und UNITI expo Stuttgart 2026 eröffnet
Die Vorbereitungen für zwei bedeutende Branchenveranstaltungen im Jahr 2026 haben begonnen: Sowohl die Carwash Show in Nashville als auch die UNITI expo in Stuttgart...
Car Wash Show 2025: Innovationen, Trends und Networking im Herzen von Las Vegas
Die führende Messe für die Autowaschbranche weltweit glänzt mit zahlreichen Innovationen
Drei Tage hatten Autowaschanlagenbetreiber aus der ganzen Welt zeit, sich über die neuesten...
AutoZum 2025
Digitalisierung und E-Mobilität im Fokus des automotiven After-Sales-Marktes
Das Jahr fängt gut an: Die AutoZum 2025, der Messe-Treffpunkt der automotiven After-Sales-Branche in Österreich, kehrt zum...
Otto Christ AG auf der Autozum in Salzburg
Die AutoZum 2024 findet vom 22. - 25. Januar 2025 im Messezentrum Salzburg statt. Mit dabei: Der Memminger Waschtechnik-Produzent Otto Christ AG mit dem...
Glänzender Erfolg: HEM und Deutschlands Autofahrer stellen neuen Weltrekord auf
Strahlender Triumph für HEM und ganz Deutschland: Am vergangenen Freitag stellte die beliebte Tankstellenkette HEM einen neuen Weltrekord auf. Mit 10.199 Autowäschen in nur...
UNITI expo Ausstellerverzeichnis ist online und zeigt die internationale Reichweite
Das Ausstellerverzeichnis der europäischen Leitmesse der Tankstellen- und Carwash-Branche ist online und zeigt, dass die UNITI expo auch weiterhin ihre globale Reichweite ausbaut.
Als internationale...
Berichte rund ums Wasser
INOWA: Erfolgreiche Fachtagung in Marchtrenk
Ressourcenschonendes Tanken und Waschen im Zeichen des Klimawandels
Viele Tankstellen- und Waschanlagenbetreiber sehen sich im laufenden Betrieb oder bei der Planung einer Neuanlage mit vielen...
Deutlich weniger Wasserverbrauch bei der Fahrzeugwäsche
Brillante Ergebnisse bei minimalem Wasserverbrauch verspricht die neue, revolutionäre Reinigungs- und Pflegemittelserie BLUE LINE® aus dem Hause POLYTOP
Jede Autowäsche verbraucht bis zu 200 Liter Trinkwasser –...
Beliebt und oft gelesen
All
- All
- 2020
- Aktuelle Frage
- Auto
- Automechanika
- Auwa
- Car Wash Show
- carwash Profi Gold-Sponsoren
- carwash Profi Sponsoren
- carwashinfo 2020
- carwashinfo Archiv
- carwashinfo LIVE
- Chemie
- Chemie
- Christ
- Coronavirus COVID-19
- cwi 2023
- cwi 2024
- Do it yourself
- E-Mobilität
- Energie
- Hersteller-News
- Interviews
- Kärcher
- Kurioses
- Messen Ausland
- Messen und Veranstaltungen
- Messeneuheiten
- News
- NuFa
- Online-Archiv
- Portalwaschanlagen
- Produkte
- SB-Plätze
- Social-Media
- Steuer/Recht
- Tankstelle & Mittelstand
- Tips
- UNITI expo
- Video-carwashprofi-2020
- Videos
- Waschmaterial
- Waschstraßen
- Waschstraßen
- WashTec
- Wasser
- Wasser
- Wasseraufbereitung
Lackkratzer nach Waschanlage?
Gericht entscheidet zu Gunsten des Anlagenbetreibers
Stellt ein Fahrzeughalter nach der Autowäsche Schäden am Fahrzeug fest, liegt die Beweislast bei ihm – er muss nachweisen,...
SVG Superwash auf der transport logistic
SVG Superwash zeigt die neue Dimension der Nutzfahrzeugwäsche „NOVA in Christ DNA“ auf der internationalen Fachmesse für Logistik, transport logistic 9.–12. Mai 2023, Messe...
Corona Krise: Unterstützung von Bund und Ländern
WOTAX warnt vor rechtlichen Fußangeln.
Erfolgreiche UNITI expo 2024
Die europäische Leitmesse der Tankstellen- und Carwash-Branche blickt auf eine weitere erfolgreiche Ausgabe mit über 18,000 Teilnehmern aus 110 Ländern und 470 Ausstellern aus...
Bakterien im Innenraum
Autofahrer sollten den Innenraum öfter und gründlicher reinigen
Eine Studie aus England bestätigt wieder einmal, dass wir mehr Öffentlichkeitsarbeit rund um die Wichtigkeit unserer Waschanlagen...
Wie nachhaltig kann Fahrzeugwäsche sein?
WashTec launcht das erste Info-Portal der Branche rund um Nachhaltigkeit – und schafft notwendige Orientierung für Betreiber und Verbraucher
Augsburg, Februar 2023 – WashTec veröffentlicht...
Neueste Artikel
All
- All
- 2020
- Aktuelle Frage
- Auto
- Automechanika
- Auwa
- Car Wash Show
- carwash Profi Gold-Sponsoren
- carwash Profi Sponsoren
- carwashinfo 2020
- carwashinfo Archiv
- carwashinfo LIVE
- Chemie
- Chemie
- Christ
- Coronavirus COVID-19
- cwi 2023
- cwi 2024
- Do it yourself
- E-Mobilität
- Energie
- Hersteller-News
- Interviews
- Kärcher
- Kurioses
- Messen Ausland
- Messen und Veranstaltungen
- Messeneuheiten
- News
- NuFa
- Online-Archiv
- Portalwaschanlagen
- Produkte
- SB-Plätze
- Social-Media
- Steuer/Recht
- Tankstelle & Mittelstand
- Tips
- UNITI expo
- Video-carwashprofi-2020
- Videos
- Waschmaterial
- Waschstraßen
- Waschstraßen
- WashTec
- Wasser
- Wasser
- Wasseraufbereitung